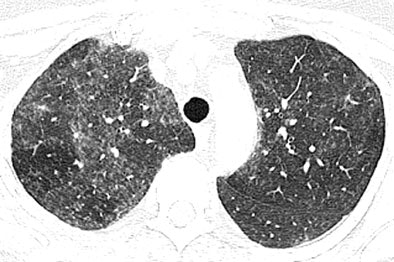
2007 03 27 14 35 41 706

Northern Californians beware: a granulomatous disease known as hot tub lung may result from exposure to Mycobacterium avium complex (MAC) in your friendly neighborhood whirlpool bath.
What's new is the pattern of findings in CT lung images following MAC exposure, as reported in the April American Journal of Roentgenology. A new survey found characteristic CT patterns of nodules and ground-glass opacities in the lungs of MAC patients who had spent time in hot tubs.
"Atypical mycobacteria cause a wide spectrum of disease in the chest," explained Dr. Thomas Hartman and colleagues from the Mayo Clinic in Rochester, MN, and Scottsdale, AZ. The most common of these, MAC, "can cause several different patterns of abnormalities" (AJR, April 2007, Vol. 188:4, pp. 1050-1053).
The classic MAC infection typically occurs in elderly men with underlying chronic obstructive disease or pulmonary fibrosis, while elderly women often get a nonclassic MAC infection characterized by bronchiectasis and small nodules or nodular infiltrates. A third category, immunocompromised patients, "often have findings that are part of a disseminated process, including nodules, masses, and miliary patterns," they wrote.
To this the literature has added hot tub lung. "It is hypothesized that contaminated water in a hot tub is aerosolized and inhaled, thereby causing a hypersensitivity-type reaction," wrote the authors, who sought to provide the first series on CT findings in pathologically proven MAC-induced hot tub lung.
From a larger study, the team retrospectively examined 12 patients (seven women, five men; average age 50 years, range 13-66) with a histologic diagnosis of granulomatous pneumonitis and positive MAC cultures. No patient was immunocompromised.
All presented with dyspnea; nine of the 12 also had a cough. Every patient had sat in a hot tub from which water samples were found to be culture-positive for MAC.
The images had been obtained on various scanners, but high-resolution images (collimation of 1-2 mm) were acquired in 11 of the 12 patients, with the 12th patient imaged at 7-mm collimation. Additional expiratory images were acquired in seven of the 12 patients, the author wrote.
Two thoracic radiologists retrospectively examined the CT data for evidence of parenchymal abnormalities, including nodules, areas of ground-glass opacities, reticular opacities, and air trapping on expiratory images, and established their diagnoses by consensus.
"Nodules were further evaluated by their centrilobular, perilymphatic, or random distribution," the authors wrote, and the extent of abnormalities was also recorded.
The results showed nodular opacities in 10 of the 12 (83%) of patients -- bilateral and symmetric in eight cases, and bilateral and asymmetric in two. The nodules involved more than 40% of the lungs in all 10 cases, according to the authors. Ground-glass attenuation (bilateral, symmetric in all cases) was seen in eight of the 12 (75%) cases, while the areas of ground-glass attenuation were diffuse in the cephalocaudal plane and randomly distributed in the transaxial plane.
![]() |
| High-resolution CT image through lungs at level of bronchus intermedius in 54-year-old woman shows nodular areas of ground-glass attenuation with centrilobular distribution bilaterally. Image republished with permission of the American Roentgen Ray Society©, from AJR 2007; 188:1050-1053 by Thomas E. Hartmann, Eric Jensen, Henry D. Tazelaar, Viktor Hanak, and Jay H. Ryu. |
In the new pattern of pulmonary disease known as hot tub lung, "centrilobular nodules and areas of ground-glass attenuation are the most common findings, and typically have diffuse but patchy distribution throughout both lungs," Hartman and colleagues wrote. Expiratory images showed evidence of air trapping in all seven cases for which they were available, they added.
![]() |
| High-resolution CT images through upper lungs in 53-year-old woman. Above, inspiratory image shows patchy areas of ground-glass attenuation bilaterally with few areas of uninvolved lung. Below, expiratory image shows air trapping in uninvolved areas of upper lungs that is more prominent on right. Images republished with permission of the American Roentgen Ray Society©, from AJR 2007; 188:1050-1053 by Thomas E. Hartmann, Eric Jensen, Henry D. Tazelaar, Viktor Hanak, and Jay H. Ryu. |
![]() |
Their findings are not specific, however, and significantly, "overlap with previously reported findings of subacute hypersensitivity pneumonitis," the team wrote. "In fact, review of the initial interpretations of the CT images included in this study indicates that hypersensitivity pneumonitis was a primary diagnostic consideration in each case."
The duration of hot tub exposure varied widely among patients, probably explained by the fact that it was the contaminated water, not the duration of hot tub exposure, that caused the condition.
Whether the disease should be treated as a granulomatous infection or a hypersensitivity reaction is a topic being debated, while the clinical course is more typical of hypersensitivity.
"Often, resolution of the symptoms occurs with removal of the patient from the vicinity of the contaminated water in the hot tub, and treatment with antituberculosis medication is usually not necessary," the authors explained.
"Regardless of whether this entity is ultimately shown to be granulomatous pneumonitis or a hypersensitivity reaction, radiologists must be aware of this new manifestation of MAC pulmonary disease," they concluded.
By Eric Barnes
AuntMinnie.com staff writer
March 28, 2007
Related Reading
CT distinguishes asbestos lung damage from smoking impairment, January 10, 2007
Indium damages LCD plant workers' lungs, January 25, 2007
X-ray features of TB reveal HIV, not reactivation, June 15, 2005
Management strategies evolve as CT finds more lung nodules, August 19, 2005
Thin-slice CT reveals severe lung abnormalities in SARS patients, July 7, 2003
Copyright © 2007 AuntMinnie.com